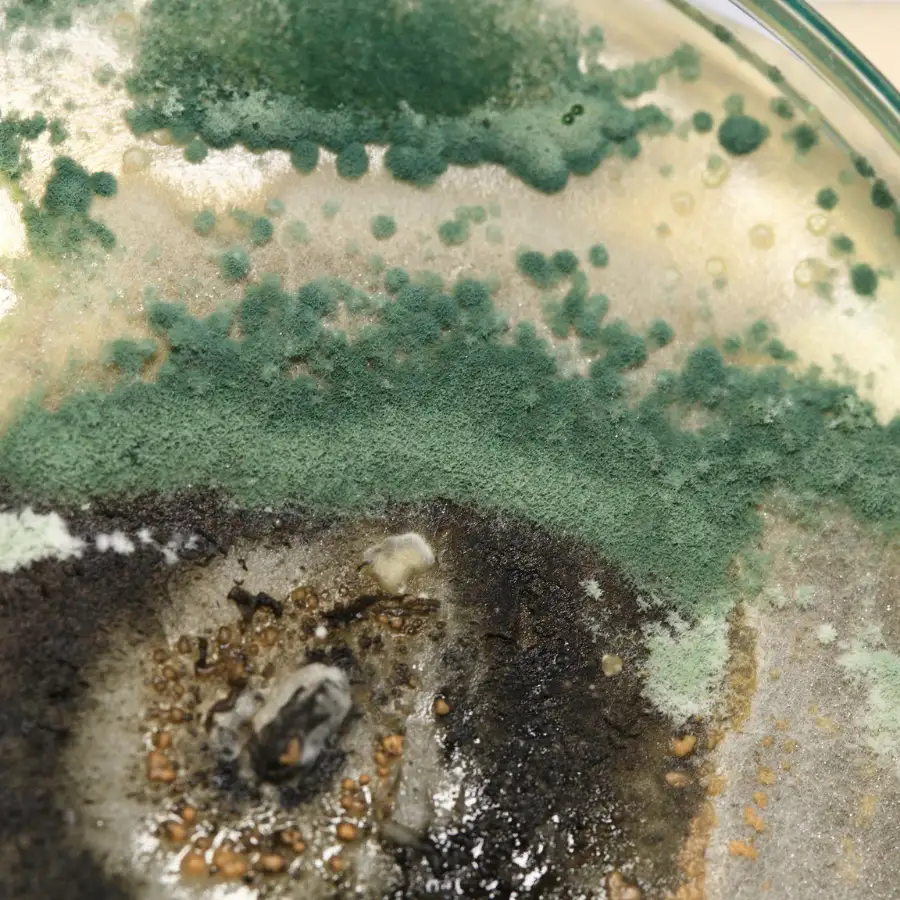

Mold Inspection Boca Raton, FL
Heavy rain, high humidity, or constant AC use can trap moisture behind drywall, in air ducts, and behind windows in South Florida homes. PureGuard Mold Removal Company assists property owners in locating concealed fungal development before it turns into a bigger indoor problem. We offer complete moisture detection, thermal imaging, spore sampling, and indoor air quality testing for residential and business properties in Boca Raton, from Mizner Park to West Boca. We check crawl spaces, ceilings, attics, and other moisture-prone areas. You will be given results, practical advice, and direction to help you understand what is occurring inside your property before problems arise.
+923015910040

What is the Mold Inspection Cost in Boca Raton?
Mold inspection charges in Boca Raton depend on property size, damaged areas, moisture conditions, and air or surface sampling. Smaller residential inspections tend to be less expensive, though larger residences or commercial facilities with hidden moisture issues could be more costly. Other factors influencing the cost are HVAC inspections, indoor air quality testing, and full reporting. A professional inspection can detect hidden moisture problems early on, providing property owners with a better understanding of indoor conditions. This is before serious structural or air quality problems occur.

Call for Support
Direct On WhatsApp
+923015910040
About PureGuard Mold Removal Company
PureGuard Mold Removal Company is available for households and business property owners in Boca Raton and adjacent areas like Delray Beach and Deerfield Beach. These homeowners want straight answers to hidden indoor moisture and air quality problems. Our staff is able to perform thorough assessments, moisture detection, environmental testing, and identify factors that could affect the safety and comfort of the interior environment. Many humidity problems in South Florida properties are caused by excessive rain, condensation from the air conditioning, and a lack of ventilation in enclosed areas. We offer a practical and no-nonsense approach, helping clients better understand what is going on inside their property without confusing technical language. Through our thorough assessments and straightforward reporting, we promote healthier indoor settings with dependable mold inspection Boca Raton services tailored to local property circumstances.

Signs You Might Need a Mold Inspection
Hidden moisture problems can quickly spread through homes and business buildings in Boca Raton. This is especially true after heavy rains, roof leaks, or extended periods of interior humidity. Many property owners ignore the early warning indicators until indoor air conditions deteriorate or obvious damage occurs to walls, ceilings, or floors. By spotting these concerns early, we can prevent larger structural and interior environmental issues.
- Stale Musty Smells: Strong musty odors indicate trapped moisture or hidden fungus growth in enclosed locations.
- Dark Spots on Walls or Ceilings: Stains around corners, vents, or drywall may indicate contamination growing beneath the surface.
- Frequent Allergy Symptoms Inside: Poor indoor air conditions could cause sneezing, coughing, headaches, or irritation inside your home.
- Water stain & damp surfaces: Hidden indoor growth thrives in areas of past leaks and moisture penetration
- Humidity & Condensation Problems: Excessive moisture in the home around windows, vents, or AC systems increases contamination hazards.
- Bubbling Drywall or Peeling Paint: Moisture trapped beneath surfaces can cause structural elements to rot over time.
Why Boca Raton Residents Prefer PureGuard
Detecting concealed moisture problems takes careful attention, local experience, and a team that understands indoor conditions common in South Florida homes. PureGuard Mold Removal Company focuses on thorough inspections, honest advice, and enabling homeowners to make wise choices. This is before minor symptoms become major interior issues. We want to offer straightforward answers and support you with reliable help, without uncertainty or tension.
- 5+ Years Local Experience: Well-versed in humidity problems impacting homes & businesses in Boca Raton.
- Extensive Property Inspections Conducted: South Florida’s preferred choice for homeowners, landlords, and commercial property managers.
- Detailed Moisture Mapping: Especially for moisture detection inside walls, ceilings, HVAC systems, and confined locations.
- Clear & Actionable Reporting: Findings are presented in a simple, uncomplicated language that property owners can easily understand.
- Residential & Commercial Property Help: Inspection assessments for homes, apartments, offices, and commercial premises.
- Indoor Safety & Prevention Emphasis: Assisting clients to recognize concerns early before moisture-related problems move deeper into the home.

What to Expect During Your Mold Inspection?
Visual Evaluation
We start with visual warning signals, recent leaks, indoor humidity problems, and spots where strange scents or moisture problems have been detected within the property.
Moisture Mapping
High-tech moisture meters and thermal imaging equipment detect moisture behind walls, ceilings, floors and other enclosed spaces where moisture may become trapped.
Full Property Inspection
Our team thoroughly inspects attics, crawl spaces, HVAC systems, vents, drywall, and moisture-prone structural locations to find issues that contribute to indoor contamination hazards.
Air and Surface Sampling
Targeted samples are taken from indoor surfaces and the air around them. This is to aid in the evaluation of airborne particles and environmental factors impacting indoor environments.
Analysis of Data
Inspection data are analyzed to identify potential sources of moisture, problematic areas, and environmental variables that contribute to hid indoor growth or poor air quality.
Reporting and Next Steps Guidance
You get a basic inspection report that provides practical advice to help property owners better understand existing issues. It recommends preventative actions going forward.

Benefits of Professional Mold Inspection
Moist or moisture problems can silently develop inside buildings long before visible damage occurs. Professional inspections are useful to uncover problems related to indoor environments early. This provides property owners with more definitive answers concerning moisture conditions, air quality concerns, and places that may need repair. This is before major problems are encountered.
Early Problem Detection
Detects hidden moisture and pollution before structural damage worsens.
Healthy Indoor Environment
Detects factors that could affect airflow and interior comfort.
Moisture Source Identification
Identifies leaks, condensation, and trouble areas related to humidity.
Property Material Protection
Early inspections can reduce long-term damage to walls, floors, ceilings, and wood surfaces.
Improved HVAC System Awareness
Spotting areas of ventilation and air circulation that can often be impacted by trapped moisture.
Clear Property Condition Reporting
Provide practical information to help property owners make an informed decision about next steps.
Peace of Mind for Homeowners & Businesses
Gives peace of mind by assisting you to find unseen indoor issues before they get more serious.
Areas We Serve
We offer professional mold inspections, indoor air quality assessments, moisture detection, and mold removal & remediation services across Boca Raton and the surrounding areas listed below. In these neighborhoods, humidity, storm moisture, and interior dampness are typical factors affecting residential and commercial premises.
- Delray Beach
- Boynton Beach
- Deerfield Beach
- Highland Beach
- Pompano Beach
- Coconut Creek
- Parkland
- Hillsboro Beach
- Boynton Beach
What Boca Raton Homeowners Are Saying
Rapid Emergency Response — Safe & Eco-Friendly Mold Treatment
Frequently Asked Questions
Get basic facts on typical indoor moisture problems, testing methodologies, air quality inspections and the health of homes and businesses across Boca Raton.
What techniques for mold inspection do experts in Boca Raton use?
Professional inspectors employ a range of tools to locate hidden indoor moisture and probable contamination behind walls, ceilings, HVAC systems and in enclosed spaces. These include thermal imaging, moisture meters, air sampling, surface sampling and visual assessments.
Where can I arrange a mold inspection near Boca Raton?
Local indoor environmental consultants are available to property owners throughout South Florida neighborhoods to perform moisture detection, air quality testing and full property inspections. For this you can contact PuerGuard mold removal company.
Are mold inspections worth it?
Inspections can discover hidden moisture situations that can prevent structural damage, indoor air quality issues and broader contamination problems that become more costly to fix later.
What is included in a full mold inspection report?
A complete report typically covers inspection findings, moisture readings, affected areas, air or surface sampling data, potential moisture sources, indoor condition assessment, and practical recommendations for further steps.
When do you require a mold examination by a professional?
Some common signs to look out for include musty smells, water damage, excessive humidity, bubbling/peeling paint, frequent allergy problems, condensation around vents or windows, and stains on walls or ceilings.
Can a moldy house be repaired?
Yes, under many circumstances. Early inspection and effective remediation measures can help to restore interior conditions, remove contaminated materials, reduce moisture problems and prevent contamination from spreading further throughout the property.
Get a 10% Discount Until The End of This Month
Do You Need Any Help?
Call Us Now
+123-234-1234
Talk to Us
hello@awesomesite.com
Rodent Control Overview
Lorem ipsum dolor sit amet, consectetur adipiscing elit. Aliquam ornare nisi at dui laoreet, eu vulputate felis fringilla sel. Quisque augue velit, elementum vel ornare vitae, mollis vel mi. Nam laoreet turpis vel quam pharetra, commodo auctor dolor tincidunt. Suspendisse quis neque id elit imperdiet porttitor eget nec libero. Donec dignissim enim nec iaculis feug. Donec interdum ipsum lorem, at semper nunc malesuada eget. Sed feugiat tellus fringilla lectus condimentum, venenati elementum est congue. Pellentesque a efficitur tellus, sed consectetur urna. Cras commodo, nunc eu tincidunt.
Key components of rodent control include:
- Identification
- Prevention
- Monitoring
- Trapping & Removal
- Baiting
- Exclusion
- Sanitation
- Environmental Management
- Regular Inspections
- Consulting Professionals
Lorem ipsum dolor sit amet, consectetur adipiscing elit. Aliquam ornare nisi at dui laoreet, eu vulputate felis fringilla sel. Quisque augue velit, elementum vel ornare vitae, mollis vel mi. Nam laoreet turpis vel quam pharetra.
Here are the key advantages of effective rodent control:
01.
Prevention of Disease Transmission
Rodents can carry and transmit diseases such as Hantavirus, Salmonella, and Leptospirosis. Controlling rodent populations helps reduce the risk of disease transmission to humans.
02.
Protecting Property
Rodents can cause significant damage to property by gnawing on electrical wiring, wood, insulation, and other materials. Rodent control helps prevent costly structural damage.
03.
Reducing Allergies and Asthma
Rodent droppings, urine, and dander can trigger allergies and exacerbate asthma symptoms in sensitive individuals. Controlling rodents reduces indoor allergen exposure.
04.
Minimizing Food Contamination
Rodents can contaminate food supplies by gnawing through packaging and leaving behind feces and urine. Effective rodent control safeguards food safety.
05.
Preserving Inventory
In commercial settings, rodents can damage stored goods and inventory. Controlling rodents protects business assets and reduces financial losses.
